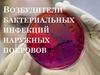
Возбудители бактериальных инфекций наружных покровов

Similar presentations:
Бактериальные кровяные инфекции и инфекции наружных покровов
1.
ЧАСТНАЯ БАКТЕРИОЛОГИЯКРОВЯНЫЕ ИНФЕКЦИИ
ИНФЕКЦИИ НАРУЖНЫХ ПОКРОВОВ
2.
КРОВЯНЫЕ ИНФЕКЦИИСпирохеты возвратного тифа - возвратный тиф
Риккетсии - сыпной тиф
Палочка чумы - чума
Палочка туляремии - туляремия
3.
ВОЗВРАТНЫЙ ТИФ(TYPHUS RECURRENS) —
СОБИРАТЕЛЬНОЕ НАЗВАНИЕ, ОБЪЕДИНЯЮЩЕЕ
ЭПИДЕМИЧЕСКИЙ (ПЕРЕНОСЧИК ВОЗБУДИТЕЛЯ — ВОШЬ) И
ЭНДЕМИЧЕСКИЙ (ПЕРЕНОСЧИК ВОЗБУДИТЕЛЯ — КЛЕЩ)
СПИРОХЕТОЗЫ (ВОЗБУДИТЕЛЬ СПИРОХЕТЫ),
ПРОТЕКАЮЩИЕ С ЧЕРЕДОВАНИЕМ ПРИСТУПОВ
ЛИХОРАДКИ И ПЕРИОДОВ НОРМАЛЬНОЙ
ТЕМПЕРАТУРЫ ТЕЛА.
4.
Эпидемический возвратный тиф - антропоноз. Специфическиепереносчики - платяная, головная вши. Человек заражается
возвратным тифом при втирании гемолимфы раздавленных вшей
в кожу при расчесывания места укуса.
Эндемический возвратный тиф — зооноз. Резервуар - грызуны,
клещи. Человек заражается через укусы клещей.
Возбудитель. Спирохеты - очень подвижны, грам «-»
Клиника. Общая симптоматика для обоих тифов - острое начало
с потрясающим ознобом, приступообразной, высокой
температурой (38—39°С и выше), сильные боли в мышцах,
головные боли, тошнота, рвота, увеличение печени, селезенки.
Диагностика. Бактериолоческий метод (кровь), серологический
метод.
Профилактика. Специфическая профилактика не проводится.
Неспецифическая профилактика сводится к борьбе с
педикулезом, в эндемических очагах — с клещами и грызунами.
5.
Эпидемический возвратный тифЭндемический возвратный тиф
6.
риккетсиозные заболевания- сыпной тиф
- эндемический (крысиный) сыпной тиф,
- клещевой сыпной тиф (североазиатский
иксодориккетсиоз)
- лихорадка Ку.
Первым наблюдал в крови и в клещах переносчиков возбудителя
пятнистой лихорадки Скалистых гор в 1909 г. американский
микробиолог Риккетс (Ricketts, именем которого и был назван
возбудитель (Rickettsia rickettsii).
В 1913 г. чешский микробиолог С. Провацек впервые наблюдал
аналогичные микробы у вшей,
кормившихся кровью больных сыпным тифом.
Оба ученых заразились сыпным тифом и
умерли.
7.
СЫПНОЙ ТИФВОЗБУДИТЕЛЬ - РИККЕТСИИ
ПРОВАЧЕКА
Острое инфекционное заболевание,
передающееся от больного человека
здоровому через вшей(переносчик).
Грамм-отрицательные, мелкие бактерии,
облигатные внутриклеточные паразиты.
Риккетсии не имеют спор и жгутиков.
Токсины риккетсии Провачека угнетают деятельность
нервной системы и вызывают парез кровеносных сосудов.
Свойства риккетсий:
- нестойкие к нагреванию (при кипячении погибают мнгновенно),
- при низких температурах сохраняются долго.
- паразитируют в эндотелиях сосудов и серозных оболочек,
- все риккетсии чувствительны к тетрациклинам,
- риккетсии способны в течение многих лет сохранятся в организме
переболевшего и вызывать повторные заболевания
(могут возникнуть с интервалом в 20 – 30 лет) – болезнь Брилла.
8.
Источник инфекции – больной человек, начиная с последних днейинкубационного периода и до 7 дня нормальной температуры (20
дней).Вошь не переносит высокую температуру – старается перепрыгнуть на
здорового человека, у которого нормальная температура.
Книника
Развивается нарушение проницаемости кровеносных
сосудов. На коже образуются розеллы с геморрагиями
в центре. Наиболее интенсивно поражаются сосуды головного мозга.
Сыпной - поражение кожных покровов) тиф - помутнение сознания –
поражение ЦНС.
Изменения происходят и в других органах – сердце, почки, селезенка, печень
и т.д. Выраженная интоксикация. Лихорадка.
Диагностика – серологический метод.
Профилактика – лечение педикулеза,
изоляция больных
9.
10.
11.
ЧУМА́ (ЛАТ. PESTIS — ЗАРАЗА)ВОЗБУДИТЕЛЬ - ЧУМНАЯ ПАЛОЧКА
(YERSINIA PESTIS)
Чума- природно-очаговое заболевание, относящееся к
группе особо опасных инфекций и характеризующееся
тяжелой интоксикацией, серозно-геморрагическим
воспалением лимфатических узлов, легких и других органов, и возможным
септическим течением.
Возбудитель - грамм «-» палочка, очень вирулентна, вырабатывает
экзотоксины.
Вне организма неустойчива. Чувствительна к нагреванию, солнечным лучам,
высушиванию. Обычные рабочие концентрации дезинфицирующих
растворов губительны для чумной палочки.
Естественный резервуар - мелкие грызуны и зайцеобразные.
Переносчик - вши
12.
ЦИКЛ РАЗВИТИЯ ЧУМНОЙ ПАЛОЧКИ13.
Механизм заражения.- При контакте с инфицированными животными (снятие шкурок, разделка туш и т.д.)
- Предметы обихода (загрязненные чумным микробом)
- Трансмиссивное (через укусы инфицированных блох)
- Алиментарным путем (употребления инфицированного мяса и др.)
- Воздушно-капельный (от больных людей и кошек с легочной формой чумы),
летальность 80-90%
После перенесенного заболевания формируется иммунитет, который не может
защитить от повторных случаев заболевания, особенно связанных с массивным
инфицированием.
Клиника. Типично острое и внезапное начало заболевания. Резкий подъем
температуры до 39-40 С, сильный озноб. Интоксикации: сильная головная боль и
головокружение, чувство разбитости, мышечные боли, жажда. Иногда тошнота и
рвота (при тяжелом течении «кофейной гущей»).
Речь у больных невнятна, походка – шатающейся. Изменения со стороны ЦНС –
суетливость, психомоторное возбуждение, нарушения координации движения,
спутанность сознания, бред. .
Если присоединяются галлюцинации (устрашающие), то больные пытаются вскочить
с постели и бежать («бежит как очумелый»).
Бубонная форма
Кожная форма
14.
Диагностика.- Бактериоскопический метод;
- Бактериологический метод;
- Серологический метод;
Пунктат бубона, отделяемое язвы, мокрота, слизь из ротоглотки, кровь, моча, кал
или секционный материал.
Материал взятый на исследование, транспортируют в специальные
противочумные лаборатории только в сопровождения медперсонала
Все больные даже при малейшем подозрении на чуму подлежат обязательной
госпитализации в специально выделенные боксы инфекционных стационаров.
В боксе, где находится больной, необходимо заклеивают вентиляционные люки,
окна и двери. Проветривание помещения через окна (форточки)
категорически запрещается.
Медперсонал, осуществляющий лечение и уход,
должен обязательно находиться в защитных
противочумных костюмах.
Костюм врача, который
носили во время вспышки
чумы в Марселе в 1720 г.
15.
16.
Впервые вакцину против чумысоздал в начале XX века Владимир
Хавкин (лечебная противочумная
сыворотка).
Важнейшими направлениями
профилактики являются
предупреждения заболеваний в
энзоотических очагах,
исключения завоза инфекции из
этих очагов, дератизационные
работы, ранее выявление
подозрительных на чуму лиц и их
изоляция.
Вспышки заболевания до сих пор
встречаются в некоторых странах
Азии, Африки и Америки.
17.
ИНФЕКЦИИ НАРУЖНЫХ ПОКРОВОВБацилла сибирской язвы - сибирская язва
Клостридия столбняка - столбняк
Клостридия газовой гангрены - газовая гангрена
Бледная спирохета – сифилис
Гонококк - гонорея
Хламидии - урогенитальный хламидиоз, трахома
Синегнойная палочка – гнойно-воспалительные
болезни
Стрептококк группы А - рожа
18.
СИБИРСКАЯ ЯЗВАВозбудитель заболевания — Bacillus anthracis —
сибиреязвенная бацилла, в организме человека и
животных образуют капсулы, грам «+», факультативные анаэробы,
вырабатывает токсин.
Очень неустойчива во внешней среде — быстро погибает при нагревании
и использовании обычных дезинфицирующих средств.
Спора может часами находиться в дезинфицирующих растворах
и выдерживает до 20 минут кипячения. В таком виде бацилла может
сохраняться в земле несколько десятков лет.
Возбудитель передается людям через продукты, приготовленные из
инфицированного материала, особенно мяса:
при уходе за больными животными;
обработке животного сырья;
через кровососущих насекомых - слепней,
мух-жигалок;
аэрозольным путем болезнь старьевщиков);
при контактах со шкурками и кожей от больных животных.
19.
Сибирская язва - антропозооное, острое особо опасное инфекционное заболеваниедомашних и диких животных, от которых заражаются и люди.
Три основных клинических формы:
кожная, легочная и кишечная.
Токсин действует на ЦНС, препятствует фагоцитозу
может приводить к летальному исходу.
Книника. Общее состояние больного тяжелое: температура 0°С,
головная боль, увеличение лимфатических узлов. Легочная форма
характеризуется высокой температурой, развитием бронхопневмони.и, тяжелой
При кишечной форме наблюдаются боли в животе, вздутие,
диспепсические явления. При легочной и кишечной формах —
заболевание заканчивается смертью больного.
Диагностика. Бактериологический и серологический методы.
Иммунитет. При сибирской язве нестойкий, возможны повторные заболевания.
Профилактика. Профилактические мероприятия проводит ветеринарная служба.
Специфическая профилактика — введение живой сибиреязвенной вакцины Вакцинацию
проводят по эпидемиологическим показаниям лицам, связанным с животноводством.
Иммунитет после прививки сохраняется до года.
20.
СТОЛБНЯКВОЗБУДИТЕЛЬ КЛОСТРИДИЯ СТОЛБНЯКА
Возбудитель - облигатно анаэробная грамположительная спорообразующая подвижная
палочка Clostridium tetani. Споры располагаются терминально, придавая бактериям
вид «барабанных палочек» или «теннисных ракеток».
С. tetani образуют сильнодействующий экзотоксин.
В почве, испражнениях и на различных предметах споры могут
сохраняться годами.
Выдерживают температуру 90 °С в течение 2 ч.
Столбнячная палочка погибает в течение нескольких минут при кипячении.
Антисептики и дезинфектанты убивают возбудитель столбняка в течение 3-6 ч.
Резервуар и источник инфекции - травоядные животные, грызуны, птицы и человек.
Столбнячная палочка также широко распространена в почве и других объектах
внешней среды. Из почвы с пылью бактерии могут попадать
в любые помещения (перевязочные и операционные блоки),
на различные предметы и материалы, применяемые
в хирургической практике (различные порошки, гипс)
21.
Столбняк (лат. Tetanus) - зооантропонозное бактериальное остроеинфекционное заболевание с контактным механизмом передачи
возбудителя, характеризующееся поражением нервной системы и
проявляющееся тоническим напряжением скелетной
мускулатуры и генерализованными судорогами.
Механизм передачи - контактный; через повреждённые
кожные покровы и слизистые оболочки
(раны, ожоги, отморожения). Местом входных ворот возбудителя могут
быть открытые раны (проколы, занозы, порезы, открытые переломы,
ожоги, отморожения, укусы, некрозы, воспалительные процессы).
Клиника Возбудитель в виде спор проникает в организм. При
анаэробных условиях в ранах происходят развитие и размножение
вегетативных форм, сопровождающиеся выделением экзотоксина. По
двигательным волокнам периферических нервов и с током крови
токсин проникает в спинной, продолговатый мозг. Развивается
паралич , возникают тетанические судороги. Возможно поражение
дыхательного и сосудодвигательного центров и ядер блуждающего
нерва (бульбарный столбняк), что нередко приводит к смерти
больных.
22.
Профилактика.Активная иммунизация. Все неиммунизированные и
иммунизированные не полностью взрослые, в том числе
выздоравливающие после столбняка, должны быть
вакцинированы.
(АДС)
Профилактика столбняка при ранениях.
При любом ранении врач должен определить показания к
пассивной (противостолбнячный иммуноглобулин) и активной
(после 7 лет - желательно АДС для взрослых) иммунизации
против столбняка.
23.
ХЛАМИДИОЗЫCh.trachomatias
(более 20 нозологических
форм)
Трахома;
• Конъюнктивит;
• Венерическая лимфогранулема;
• Урогенитальные заболевания:
у мужчин - уретрит, везикулит, орхит, простатит.
у женщин - бартолинит, эрозия шейки матки,
эндометрит,
Ch. Psittaci - возбудитель орнитоза
24.
Хламидии(от греч. chla mys—мантия)
наличие оболочки вокруг микробных частиц.
облигатные внутриклеточные паразиты;
мелкие кокковидные грамм «-» бактерии;
чувствительны к антибиотикам;
2 – х фазный жизненный цикл:
а) внутриклеточный (ретикулярные тельца в цитоплазматических
вакуолях клетки хозяина);
б) спорообразной (элементарные тельца, обеспечивающие выживание),
высокоинфекционная форма;
растут на культуре клеток (как вирусы);
наличие клеточной стенки, ДНК, РНК.
Особенностью хламидиозов является бессимптомное течение, которое
может вызывать серьезные нарушения в организме, приводящие к
бесплодию, самопроизвольным абортам, пневмонии, полиартритам,
энтеритам, энцефаломиелитам и конъюнктивитам и т. д.
25.
ТРАХОМАВОЗБУДИТЕЛЬ - ХЛАМИДИИ
«Трахома» греч. «неровный, с шероховатой поверхностью»
Хламидии - мелкие внутриклеточные паразиты.
Размножаясь в эпителиальных клетках, хламидии образуют в цитотоплазме
скопления мелких частиц.
Возбудитель трахомы нигде, кроме конъюнктивы человека, существовать не может,
(болеют только люди).
Резервуар возбудителя - конъюнктива переболевших.
Механизм передачи – контактный, контактно-бытовой.
Трахома - хроническое инфекционное воспалительное заболевание век,
конъюнктивы, слезных органов и роговицы, являющееся одной из главных причин
слепоты в эндемичных регионах.
Клиника: воспаление слизистой глаз. покраснение век,
отек и краснота конъюнктивы, жжение в глазах, обильные
Гнойные выделения, помутнение верхнего слоя роговицы,
Иммунитет не вырабатывается
26.
РОЖАВОЗБУДИТЕЛЬ - СТРЕПТОКОКК ГРУППЫ А
(S. PYOGENES),
Резервуар и источник инфекции - человек с различными формами
стрептококковой инфекции (вызванной стрептококками группы А) и
«здоровый» бактерионоситель стрептококка группы А.
Рожа - инфекционное заболевание, характеризующееся появлением на
коже или слизистых оболочках очагов чётко отграниченного острого
серозного или серозно-геморрагического воспаления, лихорадкой и
явлениями общей интоксикации. Болезнь склонна к рецидивирующему
течению.
Механизм передачи инфекции - аэрозольный
Основной путь заражения - воздушно-капельный, возможно контактное
заражение.
Входные ворота - различные повреждения (ранения, опрелости, трещины)
кожи или слизистых оболочек носа,
половых органов и др.
27.
Клиника. Развитие рожи связано с попаданием микроорганизмов вкожу из экзо- или эндогенных источников. В первом случае при
наличии расчесов, ранений, ссадин, царапин, потертостей,
опрелостей кожи стрептококк внедряется через них. Патологические
изменения тканей приводят к склерозу тканей, расстройству
лимфообращения, в связи с чем возникают отеки, резко
нарушающие форму и функцию органа.
Осложнения
Заболевание осложняют абсцессы, флегмоны, глубокие некрозы
кожи, язвы, тромбофлебиты.
Вследствие лимфовенозной недостаточности, прогрессирующей при
каждом новом рецидиве заболевания (особенно у больных часто
рецидивирующей рожей), в 10-15% случаев формируются
последствия рожи в виде лимфостаза (лимфедемы) и слоновости
(фибредемы).
Профилактика.
Мероприятия в эпидемическом очаге .
Диспансерное наблюдение за реконвалесцентами рожи
28.
КОНТАКТНО-БЫТОВЫЕЗаболевания, передающиеся половым путем
(сифилис, гонорея)
29.
ГОНОРЕЯВОЗБУДИТЕЛЬ - ГОНОКОКК
NEISSERIA GONORRHOEAE
Грамоотрицательный бобовидный диплококк микроорганизм внешним видом похожий на зерна кофе
Открыт в 1879 году Альбертом Нейссером
Гонорея - это инфекционное заболевание, передающееся
преимущественно половым путем (контактный путь - при
передаче от матери к новорожденному в родах),
характеризующееся поражением слизистых мочеиспукательного
канала и цервикального канала, что проявляется нарушением
мочеиспускания (в основном у мужчин) и воспалением шейки
матки - у женщин
Пути заражения – половой, от матери –ребенку.
Диагностика. Бактериологический и серологический методы.
Иммунитет не вырабатывается.
30.
БактериоскопияN - нейтрофильные лейкоциты.
Хорошо видны сегментированные ядра,
цитоплазма практически не видна
Gn - гонококки, заполняя лейкоциты
изнутри, обрисовывают контуры последних
Электронная микроскопия
Характерная форма гонококка - диплококк (парный кокк).
Диплококк сравнивают с кофейными зёрнами
или почками, обращёнными вогнутыми
Сторонами друг к другу
31.
СИФИЛИСВОЗБКДИТЕЛЬ – БЛЕДНАЯ СПИРОХЕТЕ
SPIROCHAETA PALLIDA.
Хроническое инфекционное венерическое заболевание,
которое может поражать все органы, в том числе кожу,
висцеральные органы, нервную систему.
Возбудитель сифилиса — бледная трепонема, или спирохета, открыта Шаудином и Гоффманом в 1905
г. Она вызвана бледной вследствие того, что слабо воспринимает окраску. В затемненном поле
зрения микроскопа трепонема выглядит в виде тонкой спиралевидной нити со штопорообразными,
правильными, равномерными завитками, число которых 8 — 15.
Пути и способы заражения. Заражение сифилисом происходит при нарушении целости кожного
покрова или слизистой оболочки: бледная спирохета внедряется в организм через трещину или
ссадину:
половой, контактно-бытовой, вертикальный.
Диагностика. Бактериоскопия Проводится в тёмном поле.
Материал для исследования - отделяемое твёрдого шанкра,
пунктаты лимфатических узлов, материал из высыпаний кожного покрова.
Серологическая диагностика
Реакция Вассермана (РСК).
32.
БОРЬБА С ПАТОГЕННЫМИБАКТЕРИЯМИ
•Соблюдение правил
личной гигиены
•Прививки и вакцины
•Ультрафиолетовый свет
и ионизирующая
радиация
•Антибиотики и другие
лекарственные
препараты
•Вещества-окислители
(йод, хлор, перекись
водорода)
•Термическая обработка
(пастеризация, кипячение,
стерилизация)
































 medicine
medicine